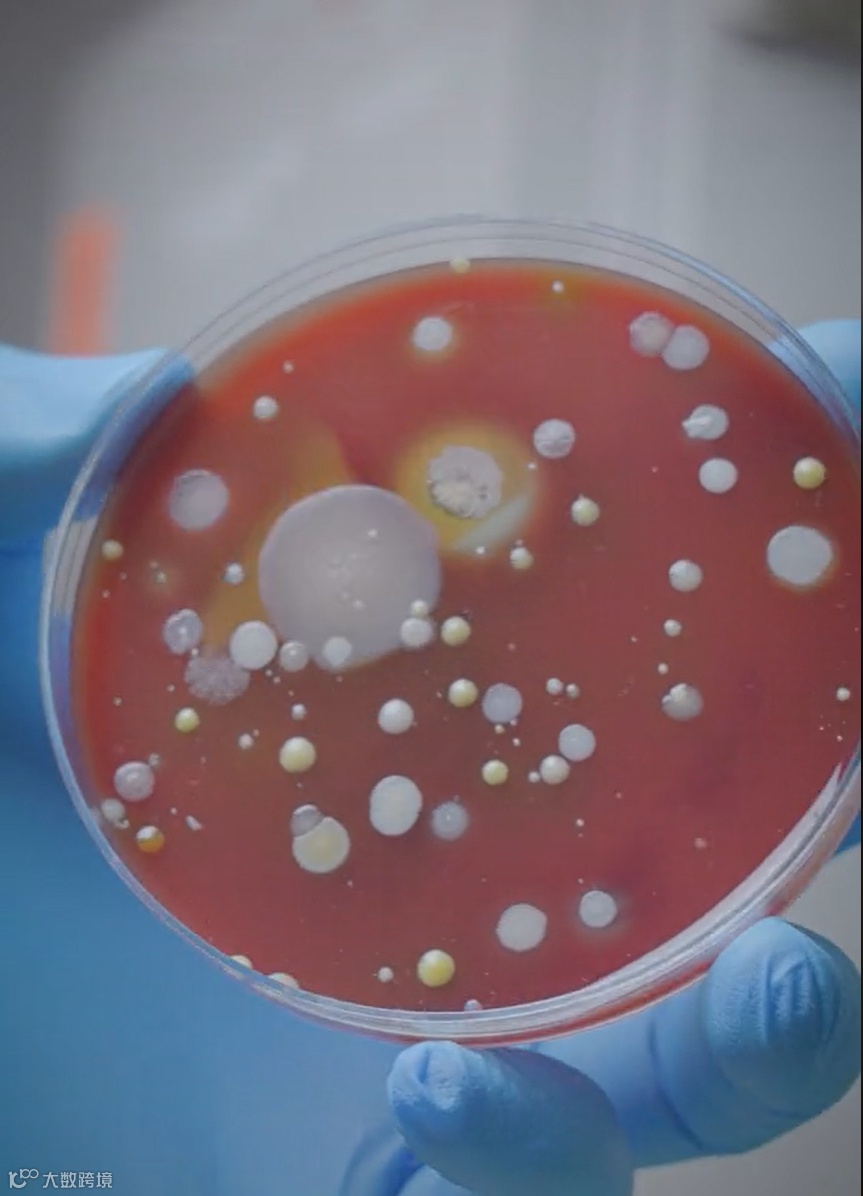

“怎么看都像是一个智商税产品,这样一个产品又是如何成为超级大爆品。”
罗永浩在一次发布会上曾经说过,根据英国某项调查测试,平均一部手机携带的细菌数量是马桶细菌数量的 10 倍!

关于"手机比马桶还脏"的说法,确实有一定的科学依据。
手机是我们每天都密切接触的物品之一,细菌和病毒很容易通过接触传播到手机表面。另外,手机放置在各种公共区域物体表面上,如桌面、公共交通工具、餐桌等,这些表面可能被其他人带来的细菌和病毒污染。这些污染物可以通过接触传播到手机上。
手机需要定期清洁,很合理!
但是我们消费者会为清洁手机花费多少费用呢?会有人为此支付 80 美元,五百多人民币么?
这就有点魔幻了!

今天我们来看的案例,PhoneSoap,是美国创业真人秀节目 Shark Tank《创智赢家》中最成功的项目之一。
如何说服大众购买一个可有可无,非刚需产品,PhoneSoap 非常巧妙地应用了恐惧营销作为宣传点,我们通过这个案例来解读消费者购物流程和恐惧营销背后的原理。
PhoneSoap 是一家专门生产手机消毒设备的品牌。创始人 Dan Barnes 在一次旅行中偶然了解到他的手机比公共厕所的马桶座还要脏,并且了解到手机是潜在的细菌和病毒传播媒介。从而促使他与合作伙伴 Wes LaPorte 开发一种方便易用的手机消毒设备,可以有效地消除手机表面的细菌和病毒。
PhoneSoap 设备外形类似一个小型盒子,具有一个可放置手机的内部仓。用户只需将手机放入仓内,并关闭设备的盖子,然后启动设备。设备内置的紫外线灯会自动启动,辐射手机表面,杀灭细菌和病毒。同时,设备还配备了充电功能,可以在手机消毒的同时给手机充电。

这一产品看似是某种可能带来严重卫生和健康隐患问题的解决方案。
但问题是,消费者会买单么?如果要为手机清洁和消毒,成本低到忽略不计的酒精湿巾难道不行么?
创业初始,创始人登上了创业真人秀节目 Shark Tank《创智赢家》寻求融资。在节目中,几位投资人也同样质疑这一类型的产品能否被市场所接受。
投资大佬罗伯特·赫贾维克 (Robert Herjavec) 说:“大部分消费者相对懒惰,我不确定他们会为这样一个小问题花钱。”

不过,依旧有几位投资人认为 PhoneSoap 是非常有潜质的产品。
投资人之一,库班(Cuban)认为,尽管 2C 市场前景存疑,但是在 2B 市场(医疗机构等),购置这一类设备为流动顾客的手机消毒杀菌,商业价值逻辑完全成立。
电视购物女王,洛瑞·格雷纳(Lori Greiner),非常坚定地相信这一产品的2C市场的巨大潜力。

“我想拿下这个产品,在我的电视购物节目中推广,就能卖几十万美元。” 她说。
最终获得洛瑞·格雷纳投资的 PhoneSoap 被证明是一款备受欢迎的产品。在洛瑞的电视购物节目中,最高峰时单日销量超过 250,000 件。疫情期间,PhoneSoap 不出意料地爆单了,即便是在疫情过去后的 2022 年,年销售依旧高达一千三百万美元
PhoneSoap 的成功不仅仅归因于其独特的产品,背后的专业营销团队非常清楚地知道,传递什么信息来说服消费者购买这样一个可有可无,非刚需产品。
在 TikTok 上,PhoneSoap 制作了有一个名为“到底有多细菌(How germy is it?)”系列的视频。

为了更直观地让人感受到公共场所的烘手器有多脏, PhoneSoap 内容团队去了加油站、电影院和商店的几个厕所,在干手器下放了一个培养皿收集样本。再将所有的培养皿放入培养箱中进行细菌培养,3 天后取出培养皿观测细菌成长。

非常不建议饭后观看,肆意成长的细菌斑点肉眼可见的触目惊心和令人作呕!
“到底有多细菌(How germy is it?)” 这一系列视频收获了海量海量的播放。那么,PhoneSoap营销团队制作这一系列视频要实现什么目的呢?背后的逻辑是什么呢?
这种内容创意是非常典型的恐惧营销策略,旨在通过激发人们内心的恐惧和不安感来推动产品或服务的销售。这种策略通常会利用人们对潜在威胁、风险或不愉快经历的担忧,以唤起他们的情绪反应,并激发购买行为。
一般来说,消费者的购物流程可以概括为以下几个阶段:
意识阶段(Problem or need recognition):在这个阶段,消费者会通过各种渠道(例如广告、口碑、社交媒体等)了解到问题,或是风险的存在。只有在需求被唤醒,消费者才有可能主动搜索信息,有意识地找寻解决方案来满足他们的需求。
研究阶段(Information search):一旦消费者意识到他们有一个需求或想要解决一个问题,他们会开始进行研究。这个阶段包括收集和比较各种产品或服务的信息,如价格、功能、质量、品牌声誉等。他们可能会查看产品评论、浏览产品说明、对比不同品牌或商家的选项,以帮助他们做出决策。
评估阶段(Evaluation of alternatives):在这个阶段,消费者会评估他们所收集到的信息,并对各种选项进行权衡。
购买决策(Purchase):一旦消费者完成评估并确定了最佳选择,他们会做出购买决策。
后续行为(Post-purchase behavior):购买完成后,消费者会对所购买的产品或服务进行评估和体验。他们可能会提供反馈、撰写评论,或者与品牌或商家互动。这可能影响到他们未来的购买决策和品牌忠诚度。
PhoneSoap 营销团队使用的就是恐惧营销策略来针对购物过程中的"意识阶段"或"问题识别"这个环节。
这一系列内容用非常直观和极具视觉冲击力的实验呈现展示,激发人们内心的恐惧和不安感,强调问题的严重性,并促使消费者感受到这一紧迫需要解决问题。
培养皿中的细菌斑点成长的前后对比,直观且令人作呕,非常有效地触发受众恐惧、焦虑等不快的情绪。
试想一下,如果大部分消费者都没有意识到生活周边环境细菌丛生,暗藏健康危机,有怎么会愿意支付大几十美元购买一个看似无用的手机消毒器呢。
PhoneSoap 营销团队的恐惧营销策略中,给出了明确的场景(公共场合卫生间),用前后对比呈现出令消费者感知到难以承受潜在风险和危害,为的就是引导受众购买做铺垫啊。
套路,都是套路啊!



